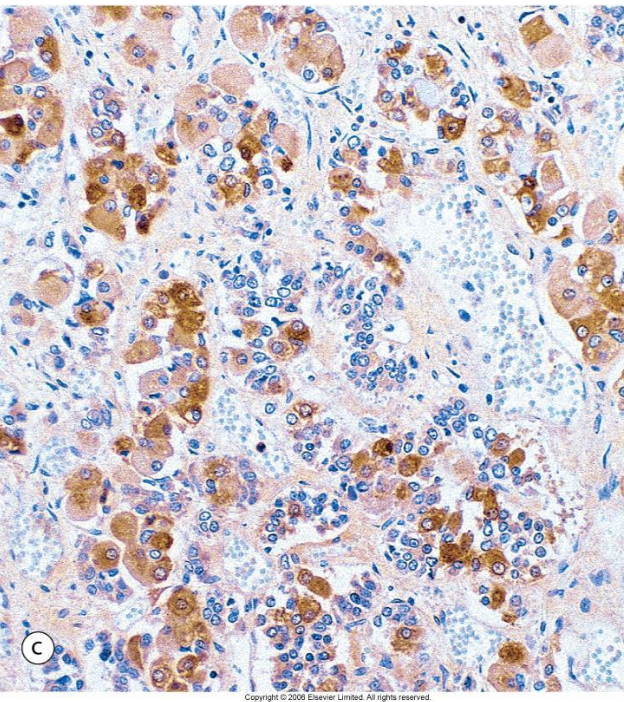

What are the primary endocrine hormones
- Pituitary gland (Hypophysis cerebri)
- Pineal gland (Epiphysis cerebri)
- Thyroid gland
- Parathyroid glands
- Adrenal glands
What are the functions of the endocrine organ
Internal environment, Energy production,
storage, and utilization, Reproduction, Growth & development
What is the role of the hypothalamus
ventral pt. of the diencephalon
Integrates nervous system + endocrine system (neurosecretory neurons)
homeostasis
No BBB
What are the two parts of the pituitary?
Anterior pituitary/adenohypophysis and Posterior pituitary/neurohypophysis
What are the three parts of the anterior pituitary
Parsdistalis
Parsintermedia
Parstuberalis
What are the two parts of posterior pituitary
Infundibulum
Parsnervosa

Located ventral to hypothalamus (H), near optic chiasm (O)
Lies in hypophyseal fossa of sella turcica (ST)
Pituitary gland (P) = 2 parts
Anterior pituitary or adenohypophysis (AP)
Posterior pituitary or neurohypophysis (PP)
Anterior pituitary envelops posterior pituitary
Origin of the anterior pituitary
Epithelial from the roof of pharynx
Origin of the posterior pituitary
Neuroectordermal from dienchephalon
Pars distalis in H&E stain

Chromophils (stimulating horomones)
- Acidophils (PRL, GH) -
- Basophils (LH, FSH, ACTH and TSH)
Chromophobes (C)
Sinusoids
Adenohypophysis:
Pars distalis immunohistochemical stain for Luteinizing Hormone (LH)
cells in the anterior pituitary are difficult to differentiate based on H&E stains
Immunohistochemical (IHC) stains have
been developed to identify the cells
Antibodies attach to LH and then a secondary stain that is easy to visualize is applied
Neoplasia and research
Adenohypophysis: pars intermedia
Species differences in size
Lies between pars nervosa and pars distalis
Contains large pale cells produce large molecule proopiomelanocortin (POMC)
POMC cleaved into endorphins, melanotropins (parenchymal cell) and lipotropins

Hormones of Neurohypophysis: posterior pituitary
Stores hormones made in hypothalamus
for release directly into blood stream
Antidiuretic hormone (ADH)
Oxytocin
Neurohypophysis : pars nervosa

Unmyelinated nerve fibres (neurosecretory)
Herring bodies (H) store ADH and oxytocin
Pituicytes (Glial cells)
- Indistinct on H&E
- Provide support
Hormones of the hypothalamo- pituitary axis
Clusters of neurosecretory neurons (paraventricular and supraoptic nuclei) that monitor HOMEOSTASIS
RELEASING HORMONES
- GnRH, TRH, CRH, GHRH, PRF
- ADH and OXYTOCIN
The pituitary gland secretes STIMULATING HORMONES

Pineal Gland
Pinealocytes secrete MELATONIN
* Blood vessels
*Neuroglial supporting cells
Responds to stimuli detected in the retina
Darkness stimulates pinealocyte secretion of MELATONIN –> circadian 24 hr rhythm
Reg. of rhythmic body activity
Seasonal reproduction
* Long day and short day breeders

Thyroid Gland
Regulated by TSH secretion
Follicles (Thyroid gland)
- Cuboidal follicular cells secrete THYROGLOBULIN
- Stored in follicle lumen (COLLOID) and combined with IODINE
- Cuboidal follicular cells convert colloid to active THYROXINE→ increases basal metabolic rate, thermogenesis, gluconeogenesis

PARAFOLLICULAR ‘C’ cells (C)
Large pale, round
Secrete CALCITONIN (in response to
increased plasma calcium)
Decreases plasma calcium
Decreased osteoclast activity– > calcium stored in bone
Increased renal excretion

What thyroid follicle is less active?

Parathyroid Gland

CHIEF CELLS secrete PARATHORMONE (PTH) in response to decreased plasma calcium
PTH increases plasma calcium
- Stimulates osteoclasts –> bone resorption and calcium release
- Increases intestinal uptake
- Increases renal resorption
Adrenal glands
Cortex originates from mesoderm (3 ZONES)
Medulla originates from neural crest
- Modified neurons and secrete catchecolamines

Layers of the adrenal cortex
Zona glomerulosa
Zona fasciculata
Zona reticularis
Zona glomerulosa
Mineralocorticoid (ALDOSTERONE→
Na+/H2O resorption and K+secretion at distal convoluted tubule→increase blood pressure)




